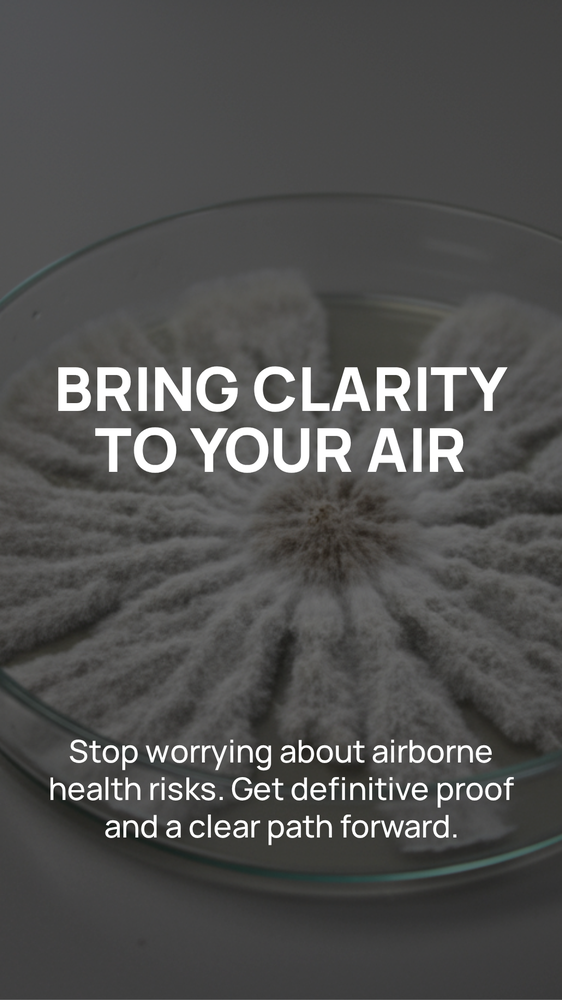
ProDetect Mold Inspection - mold inspector in West Hollywood, CA

ProDetect Mold Inspection
Mold Inspector in West Hollywood, California
Client Reviews
About ProDetect Mold Inspection
At 1112 Sherbourne Dr, Ste 104 in West Hollywood, ProDetect Mold Inspection handles environmental testing. Their 5.0-star average comes from 1 Yelp reviews. Services include environmental testing. California has some of the strictest local regulations regulations in the country.
How They Can Help
ProDetect Mold Inspection handles environmental testing in West Hollywood. Mold problems start small and get expensive fast. Whether you suspect mold after water damage or need a pre-purchase inspection, call (424) 263-6502 to discuss what you need.
What to Expect
Call (424) 263-6502 to schedule an inspection. The inspector will walk the property with a moisture meter, check problem areas, and collect air or surface samples if needed. Lab results typically come back within 2 to 5 business days.
Service Area
ProDetect Mold Inspection is at 1112 Sherbourne Dr, Ste 104 in West Hollywood, CA. They serve the local area and surrounding communities.
Frequently Asked Questions
Does ProDetect Mold Inspection do remediation too?
How long does a mold inspection take?
Does homeowners insurance cover mold?
What does ProDetect Mold Inspection inspect for?
Need a Cleaner Mold Case File?
MoldLedger helps homeowners and pros keep intake, photos, findings, and next steps in one clean case record.
Start a Case